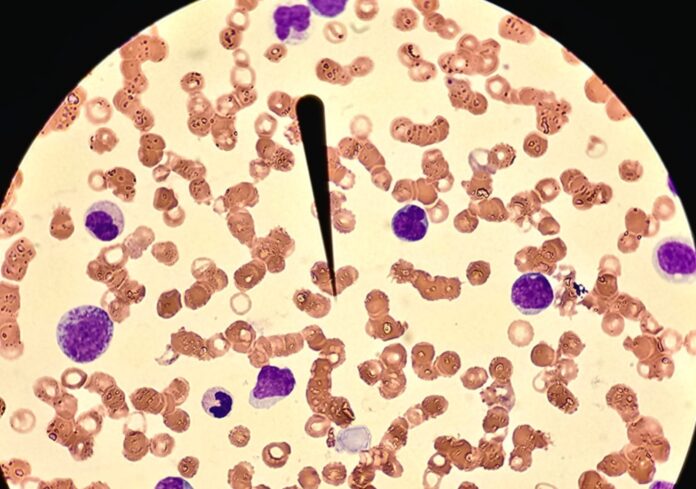

La institución cuenta con equipos automatizados de alta tecnología para un diagnóstico oportuno y confiable.
Ciudad Juárez, Chih .- Durante el primer bimestre del presente año, Pensiones Civiles del Estado (PCE) realizó 201 mil 739 estudios de laboratorio, en beneficio de 13 mil 148 derechohabientes de la delegación Chihuahua, lo que se traduce en más de 100 mil análisis mensuales.
Para estas pruebas se emplean equipos automatizados de alta tecnología, que permiten una detección y tratamiento oportunos, de diversas enfermedades.
El laboratorio clínico opera bajo altos estándares de calidad y es evaluado mensualmente a través del programa de control de calidad externo “Pacal” en cuanto a bacteriología, uroanálisis, hematología, coagulación, parasitología, inmunología y química clínica.
Solo en 2024, el centro clínico de Chihuahua efectuó 952 mil 085 estudios de laboratorio, a 84 mil 331 derechohabientes. En esta Delegación también se procesan los estudios procedentes de las sedes de Delicias, Meoqui y Cuauhtémoc.
Para mayor comodidad, los derechohabientes pueden consultar e imprimir sus resultados a través de la página institucional MiPCE.

¿Quieres compartir información o enviar boletines de prensa?
Envíanos un correo.
¿Tienes dudas? ¿Necesitas verificar alguna noticia?
No dudes en enviarnos un correo, con gusto la verificamos por tí.
Síguenos en nuestras redes sociales.